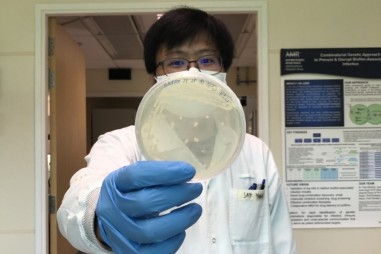
Kỹ thuật mới làm cho vi khuẩn nhạy cảm hơn với kháng sinh

Siêu tụ điện có thể sạc siêu tốc
17/09/2020
TNNN - Trong báo cáo một công trình khoa học mới, các nhà nghiên cứu thuộc Đại học Texas A&M, Mỹ đã giới thiệu thiết bị lưu trữ năng lượng, phát triển trên cơ sở thực vật có thể sạc pin ô tô điện chỉ...

17/09/2020
TNNN - Trong báo cáo một công trình khoa học mới, các nhà nghiên cứu thuộc Đại học Texas A&M, Mỹ đã giới thiệu thiết bị lưu trữ năng lượng, phát triển trên cơ sở thực vật có thể sạc pin ô tô điện chỉ...

TNNN - Sứa được đưa vào không gian để theo dõi ảnh hưởng của môi trường vi trọng lực (microgravity) đối với các sinh vật sống.

TNNN - Nhờ hệ thống cảm biến đặc biệt, loại khẩu trang mà các nhà khoa học Singapore đang nghiên cứu có thể phát hiện các trường hợp nhiễm Covid-19.

TNNN - Loại khẩu trang kháng khuẩn với sợi nano titanium dioxide có thể được khử trùng và tái sử dụng tới 1.000 lần, giảm thiểu các vấn đề về môi trường và sức khỏe cộng...

TNNN - Một công ty dược Trung Quốc đã tiêm vaccine Covid-19 thử nghiệm cho hàng trăm nghìn người, bất chấp nhiều cảnh báo từ phương Tây về việc tiêm trước khi nghiên cứu...

TNNN - Các nhà nghiên cứu ở tỉnh Chiết Giang, Trung Quốc đang phát triển một máy tính có hơn 100 triệu tế bào thần kinh như một bộ não.

TNNN - Cỗ máy gia tốc hạt lớn (LHC) sử dụng phương trình nổi tiếng của Albert Einstein E = mc2, để chuyển đổi vật chất thành năng lượng, sau đó trở lại thành những hình...

TNNN - Chlamydia là căn bệnh nhiễm trùng nghiêm trọng và là nguyên nhân gây tử vong hàng đầu cho loài gấu túi, hay gấu Koala ở Australia. Một nghiên cứu mới đã xác định...

TNNN - Giáo sư Jan CM van Hest của Đại học Công nghệ Eindhoven vừa công bố một đột phá trong điều trị ung thư không xâm lấn.

TNNN – Trong thời gian tới, các nhà sản xuất vaccine chống Covid-19 sẽ phải đáp ứng tiêu chuẩn về hiệu quả hoạt động cao hơn mức bình thường.

TNNN - Axit amin được gọi là Lys102 có thể làm các tế bào ung thư trở nên di động hơn và dễ hình thành di căn hơn.

TNNN - Một công ty của Nhật Bản phối hợp với chính quyền quận và Bệnh viện Itabashi vừa chế tạo thành công robot sử dụng tia cực tím để tiêu diệt virus Sars-CoV-2.

TNNN - Mới đây, các nhà khoa học cho biết, những "siêu chuột” được biến đổi gien đã duy trì được lượng cơ bắp trong suốt một tháng ở Trạm Vũ trụ Quốc tế.

TNNN - Thông thường cây cối và các loại thảm thực vật khác che khuất việc tìm kiếm các thi thể mất tích.

TNNN - Một loại thuốc của Nga được điều chế để điều trị các tổn thương phổi nghiêm trọng, cũng có hiệu quả trong việc chống lại Covid-19.

TNNN - Con người đã dùng chuột làm thí nghiệm trong hơn 150 năm qua và số công trình nghiên cứu khoa học dựa trên loài vật bé nhỏ, nhanh nhẹn này tiếp tục gia tăng.
TNNN - Các nhà nghiên cứu thuộc đơn vị nghiên cứu của MIT ở Singapore đã phát hiện một phương pháp mới để đảo ngược tình trạng kháng kháng sinh ở một số vi khuẩn.

TNNN - Thuốc điều trị Covid-19 được phát triển dựa trên kháng thể của bệnh nhân phục hồi và kháng thể đặc hiệu mới bằng công nghệ chip vi chất lỏng.

TNNN - Vật liệu mới dùng để chế tạo máy dò tia X linh hoạt, ít gây hại cho môi trường và tiết kiệm chi phí hơn các công nghệ hiện có.

TNNN - Liệu pháp kết hợp mới có thể vượt qua hàng rào máu não, nhắm vào các di căn não và cải thiện đáng kể khả năng sống sót.